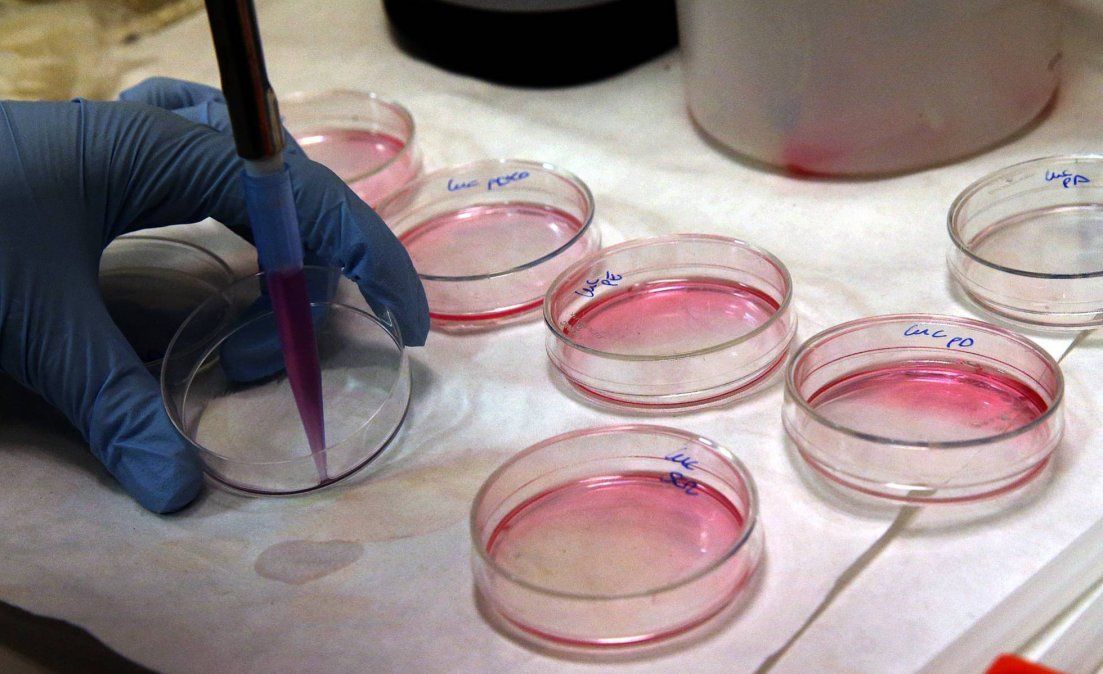
EEUU aprobó el primer tratamiento génico contra el cáncer en el mundo

EEUU aprobó el primer tratamiento génico contra el cáncer en el mundo
La agencia federal de alimentos y medicamentos de Estados Unidos, la FDA, aprobó el miércoles la comercialización de la primera terapia génica en el mundo, que consiste en modificar genéticamente el sistema inmunológico de un enfermo para combatir una agresiva forma de leucemia.
La agencia federal de alimentos y medicamentos de Estados Unidos, la FDA, aprobó el miércoles la comercialización de la primera terapia génica en el mundo, que consiste en modificar genéticamente el sistema inmunológico de un enfermo para combatir una agresiva forma de leucemia.








